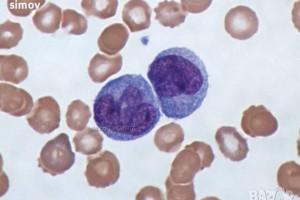
Снимка номер 1 за Азур-еозин по Романовски 99 прах-багрило за микроскопскопия.

Тесла 550 гр българска
Тесла 550 гр българска е с отвор за дръжка ф30 мм, предрага се без дръжка.
Теслата намира приложение предимно в строителната сфера, като може да се използва и за определени ремонти у дома.
Тя е практичен инструмент, чрез който могат да се коват, разковават или оформят различни детайли.
Състои се от дървена дръжка с прикрепено метално острие със заострен ръб.
За автора
Мнения от други потребители